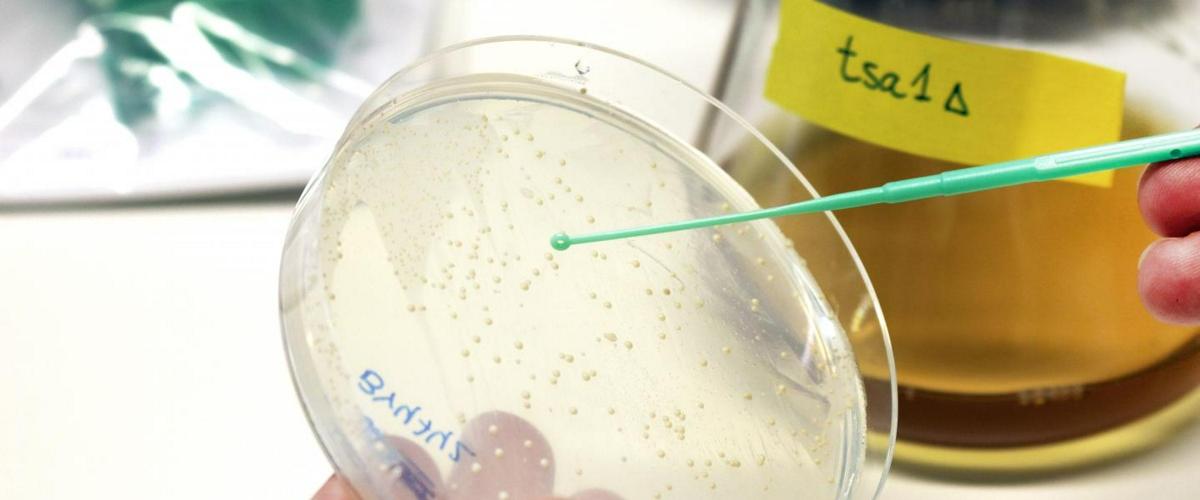
TODO:

В высоких концентрациях активные формы кислорода, также называемые оксидантами, вредны для клеток всех организмов и связаны со старением. Новое исследование шведских ученых из Чалмерского технологического института показывает, что низкие уровни оксиданта перекиси водорода может, напротив, замедлять старение клеток. О работе ученых рассказывает EurekAlert.
Эксперименты на дрожжевых клетках показали, что применение перекиси водорода стимулирует фермент Tsa1, который активизирует весь процесс. И если ранее ученые думали, что Tsa1 просто нейтрализует активные формы кислорода, то теперь они видят этот механизм с новой стороны.
Известно, что снижение потребления калорий влияет на продолжительность жизни разных организмов от дрожжей до обезьян. Теперь ученые показали, что Tsa1 использует небольшие количества оксиданта для снижения активности центрального сигнального пути, когда клетки получают меньше калорий.
В конечном итоге это приводит к замедлению процессов клеточного деления, а также защите клеток от стресса, что в результате замедляет их старение.
Открытие делает ученых на шаг ближе к пониманию механизмов, позволяющих оксидантам замедлять процессы старения. Теперь ученые намерены подробно изучить эти процессы на моделях возрастных заболеваний, чтобы найти новые стратегии для их лечения.
Ранее ученые из Швейцарии определили ключевые регуляторы старения. Используя эти данные, ученые хотят сделать старость более приятной без обременения болезнями, а не просто продлить жизнь человека.